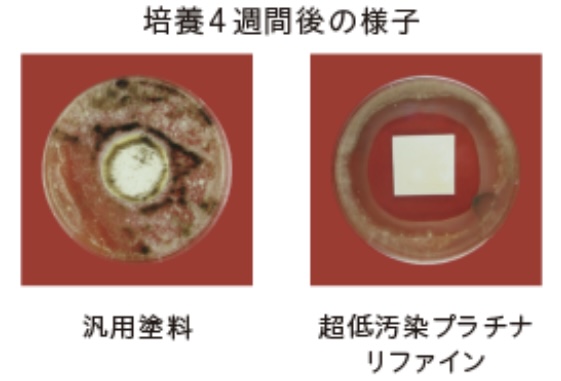
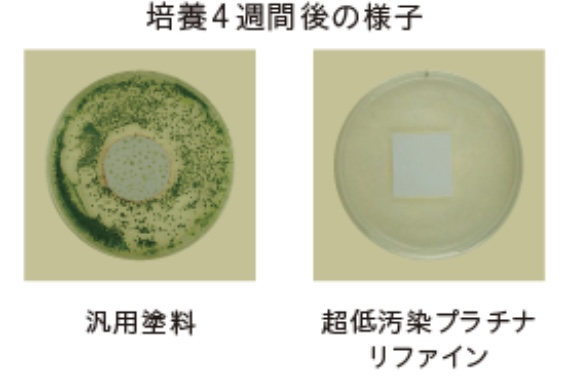

スタッフブログ
【外壁用塗料】超低汚染プラチナリファイン2000MF-IR
2026.03.27
スタッフブログ
大村市で外壁塗装・屋根塗装を専門に行っている【プロタイムズ大村店】です。
当ブログでは、外壁の劣化症状の見分け方や塗料の選び方、
工事の適切なタイミングなど、住まいを長持ちさせるための役立つ情報を発信しています。
これから外壁塗装・屋根塗装・内装・雨漏れ、その他小工事を検討されている方は、
ぜひ参考にしてください!
【超低汚染プラチナリファイン2000MF-IR】

業界最高水準の汚れにくさを実現。
「美観」×「保護」を両立する革命的超低汚染塗料
特徴・・『高耐候性』
紫外線などの劣化要因に対して高い耐性を発揮し、建物を長期間保護
促進耐候性試験(キセノンランプ式)において約21~26年相当
※経過後も光沢保持率80%以上を保持。
劣化要因に耐性を発揮する独自技術により、塗膜の劣化要因である紫外線、
雨による影響を受けにくく、建物を長期間保護します。※期待耐用年数

※あくまで試験環境下における推測値であり、耐候性を保証するものでは
ありません。実際の自然ばく露環境下では、下地の状態、施工方法、
気象条件により耐候性は異なる場合があります。
🔸紫外線に強い「フッ素樹脂」+「無機成分」により耐候性向上
規則的な交互結合のため、結合力が強く紫外線による劣化を抑える
「完全交互結合型フッ素樹脂」を採用。
さらに、劣化に強い特殊強化剤(無機成分)をフッ素結合に固着させることで、
さらなる高耐候性を実現。

🔸劣化要因ラジカルを抑える技術により、耐候性のさらなる向上を実現
ラジカルとは、塗料に色を付ける顔料の主成分である「酸化チタン」が、
紫外線の影響を受けることで発生する劣化因子です。
このラジカルが発生すると、樹脂の結合が破壊され、塗膜の劣化が
進行してしまいます。
〈ラジカル制御型白色顔料〉

ラジカルが発生しにくく、発生した場合にもシールド層がラジカル
放出を防ぐため、樹脂の破壊を抑える。
〈ラジカルを捕捉する「HALS」〉

ラジカル制御型白色顔料の補完として「HALS(光安定剤)」を配合することで、
ラジカルによる塗膜劣化を抑制する。
※HALS:Hindered Amine Light Stabilizer(光安定剤)
特徴・・『超低汚染性』
独自の無機成分配合技術により緻密な塗膜を形成し、最高水準の
“超”低汚染性を発揮
無機成分の配合により緻密で強靭な塗膜を形成。
他社と比較しても、汚れの付着・定着を抑え、長期間にわたり、
美観を維持します。

〈独自技術①緻密性〉

無機成分配合により、緻密で強靭な塗膜を形成。
粒子の細かい汚染物質も突き刺さりにくく、美観を維持。
〈独自技術②親水性〉

親水性(水になじみやすい性質)により、塗膜に汚れが付着しても汚れの
間に水が入り込み、汚れを洗い流す。
特徴・・『防カビ・防藻性』
美観を損なう「カビ」「藻」の発生を抑え美観維持に貢献
「JIS Z 2911かび抵抗性試験方法」および「藻抵抗性試験(社内試験による)」に合格。
通常配合されている防カビ・防藻剤に加えて、効果を高める薬剤を配合。
より多くの種類の菌種に対して、効果を発揮し、防カビ・防藻性を長期間維持します。
〈カビ〉
〈藻〉
特徴・・『遮熱性』
特殊遮熱無機顔料の使用によりすぐれた遮熱性を発揮
※アステック標準色8113トゥルーホワイト以外に全色で使用。
太陽光の波長のうち、温度上昇の原因となる近赤外線を効果的に
反射する塗膜を形成し、室内の温度上昇を抑えます。
※建物構造、断熱構造、開口部(ガラス窓)の大きさ・数によって温度変化の
程度に差が出ます。
〈超低汚染プラチナリファインシリーズ〉

〈従来の塗料〉

特徴・・『遮熱保持性』
長期間にわたり遮熱性も発揮
従来の遮熱塗料は、経年とともに付着した汚れが熱を吸収するため、
徐々に遮熱効果が低下していきます。超低汚染プラチナリファインシリーズは
美しさが長く続くため、汚れによる熱の吸収を抑制。従来の遮熱塗料に比べて
長く遮熱効果を発揮します。
〈超低汚染プラチナリファインシリーズ〉

汚れが付着しにくいため熱の吸収を防ぎ、遮熱性を長期間保持する
〈従来の塗料〉
付着した汚れが熱を吸収し、徐々に遮熱性能が低下する

大切なお住まい長く、美しく保つためには、
定期的な外壁・屋根塗装が欠かせません。
大村市で外壁塗装・屋根塗装など、ご検討中の方は、
ぜひ弊社へお気軽にご相談ください。
劣化状況を丁寧に診断し、最適な塗装プランをご提案いたします💡
【劣化診断・見積り・相談】無料🍀
株式会社ソエジマ【プロタイムズ大村店】
場所:〒856-0826 長崎県大村市水主町2-627-1
TEL:0120-066-116


















